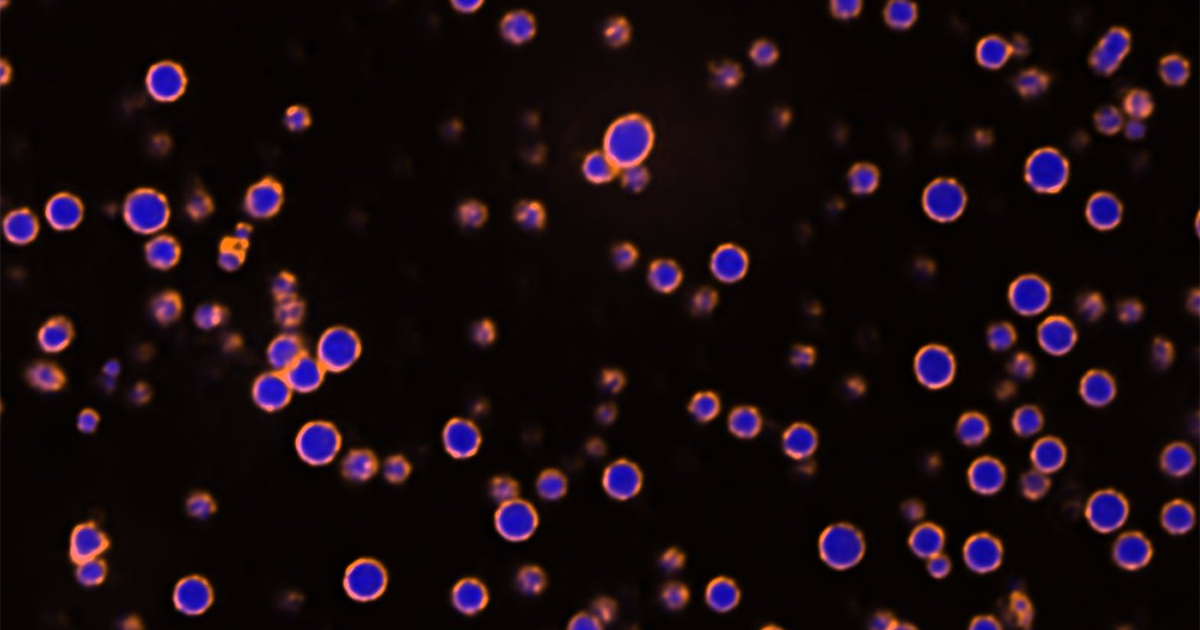
NU_BSA's tweet card. A team with Professor Krishna Shrinivas discovered how a landmark found in the nucleus of cells in many organ systems forms through a different mechanism than the well-established view, a revelation...

Department of Cell & Developmental Biology
@NU_CDB
Follow us on LinkedIn: https://www.linkedin.com/company/northwestern-university-department-of-cell-dev-biology/
You might like
A research team with Professor Krishna Shrinivas developed a machine learning framework to design flexible proteins that don’t fold into a fixed shape. The approach could enable new therapies and synthetic biology breakthroughs. spr.ly/6013AqH6V

A team co-led by Northwestern cell biologist (@NU_CDB) Wilton Snead, PhD (@wilton_snead), discovered a new mechanism driving paraspeckle formation — challenging models of nuclear condensates and offering insight for future #cancer therapies, per @PNASNews. tinyurl.com/j4t699zp
Happy to share our recent paper on the role of AK7 on centriole number and the consequence of misregulation that leads to PCD. sciencedirect.com/science/articl…
Exciting new findings from our lab! ⏳🐟 In our latest @NatureComms paper, we show that DeltaD—not just DeltaC—drives Notch signaling in zebrafish, reshaping our understanding of segmentation clock dynamics! 🔬✨ Paper: rdcu.be/ec2Yz
📣Join us this Tuesday @ 9AM the Baldwin Auditorium for a Trainee Seminar, presented by @ChandelAngad , Predoctoral Fellow in the @OzbudakLab 🧬📚

Mark your calendars! 📝 We're hosting Dr. Aryeh Warmflash for a seminar on "Studying self-organization in mammalian development with pluripotent stem cells," next Weds, Jan 15 @ 12noon at the Baldwin Auditorium

Dear imaging community! @CAM_NUChicago @NUFeinbergMed is hiring an assistant core scientist in electron microscopy. Chicago is great & our team and leader are fantastic! Please DM us if you are interested! @GlobalBioImage @BioimagingNA @LatamBioimaging higheredjobs.com/admin/details.…
📣Join us this Tuesday @ 9AM the Baldwin Auditorium for the first @NU_CDB Trainee Seminar of 2025, presented by @EmanuelleGrody, Predoctoral Fellow in the @yogeshgoyallab

New tenure-track faculty position is open in Cell & Developmental Biology. #sciencecareers #cellbio #devbio #quantbio #sciencetwitter #facultyjobs Click here to learn more: bit.ly/3tymj6k

If you're at #ASCB2024 don't miss the round table discussion led by 🔬Core Directors @MichelleItano and @ArvanitisDina on 'pulling back the curtain on a career in core facilities' @NUFeinbergMed @NU_CDB @UNC_CBP @BioimagingNA @GlobalBioImage They're both amazing! Don't miss it!

So excited to see this out in bioRxiv for the community. It was a tour-de-force, interdisciplinary, extremely fun and surprising!!!! A must read!!!!
Looking forward to this talk where @NorthwesternU @NUFeinbergMed @NU_CDB Core Directors Dina Arvanitis (CAM) and Xinkun Wang (Sequencing) will tell us about the fantastic work they are doing for our local and international community!
Join us for the final 𝗦𝗽𝗼𝘁𝗹𝗶𝗴𝗵𝘁 𝗦𝗲𝗿𝗶𝗲𝘀 𝗦𝗲𝗺𝗶𝗻𝗮𝗿 of 2024! Philip Hockberger, Constadina Arvanitis, and Xinkun Wang will explore collaborations between core facilities & industry, showing how these partnerships drive innovation & growth.

📣Thrilled to announce the winner of the Graphic Design Contest: Dr. Wen Lu, Research Assistant Professor. Her work titled "The Multi-Universe of CDB Research" will be featured in future digital and print media representing our department.🤩💫🧬

🌟 New Paper Alert! 🚨 How does a developing embryo know where to place somite boundaries? 🦴🐟 Our latest study authors.elsevier.com/a/1kATe5Sx5gxl… in @Dev_Cell reveals a missing piece of the puzzle involving ERK oscillations and the segmentation clock (nature.com/articles/s4158…) (1/)

Dr. Stuart Stock was the first user running an experiment at Beamline 1-ID of the Advanced Photon Source (APS - @advancedphoton ) after APS's upgrade.

We are excited to be hosting Dr. Smita Krishnaswamy, Professor at @yale in genetics and computer science, this November 13th for a special seminar on “Inferring and Characterizing Cellular and Neural Dynamics with Geometric and Topological Deep Learning”.

I am very excited to share that I'll be starting as an assistant professor in the Department of Cell & Developmental Biology at Northwestern (@NU_CDB) in 2025!
The paper by Sun Kin in the lab in collaboration with Steve Rogers (UNC) biorxiv.org/content/10.110… has been accepted for publication in MBoC. Congratulations, Sun!
📢Voting in the #JCSImagingSI cover competition is open. We'll be highlighting all the shortlisted images this week! Vote number 9 for ‘Intricate Interactions: The Dance of Microtubules and Actin’ from Wen Lu (@volodya_gelfand lab). focalplane.biologists.com/2024/09/25/vot…

United States Trends
- 1. #BaddiesUSA 51.6K posts
- 2. Rams 28K posts
- 3. Cowboys 97.4K posts
- 4. Eagles 137K posts
- 5. Scotty 8,983 posts
- 6. #TROLLBOY 1,722 posts
- 7. Chip Kelly 7,936 posts
- 8. Stafford 13.9K posts
- 9. Bucs 12K posts
- 10. Baker 20.6K posts
- 11. Raiders 65.5K posts
- 12. #RHOP 10.7K posts
- 13. Stacey 29.6K posts
- 14. #ITWelcomeToDerry 13.4K posts
- 15. Todd Bowles 1,948 posts
- 16. Teddy Bridgewater 1,160 posts
- 17. Ahna 6,106 posts
- 18. Lemmy 4,447 posts
- 19. Shedeur 129K posts
- 20. Vin Diesel N/A
You might like
-
 Gottardi Lab
Gottardi Lab
@GottardiLab -
 Northwestern Basic Sciences
Northwestern Basic Sciences
@NU_BSA -
 Vladimir Gelfand
Vladimir Gelfand
@volodya_gelfand -
 Uri Manor
Uri Manor
@manorlaboratory -
 G.W. Gant Luxton, PhD 🏳️🌈🔬
G.W. Gant Luxton, PhD 🏳️🌈🔬
@gwgl1979 -
 Dileep Varma
Dileep Varma
@DileepVarmaLab -
 Vipul Shukla
Vipul Shukla
@vipulshukla08 -
 Jaehyuk Choi
Jaehyuk Choi
@jaehyukchoimd -
 LeritLab
LeritLab
@LabLerit -
 Northwestern BMG and SQE
Northwestern BMG and SQE
@NU_BMG_SQE -
 NU Center for Advanced Microscopy & NIC
NU Center for Advanced Microscopy & NIC
@CAM_NUChicago -
 Dr. Lisa Cameron
Dr. Lisa Cameron
@MicroscopyLAC
Something went wrong.
Something went wrong.